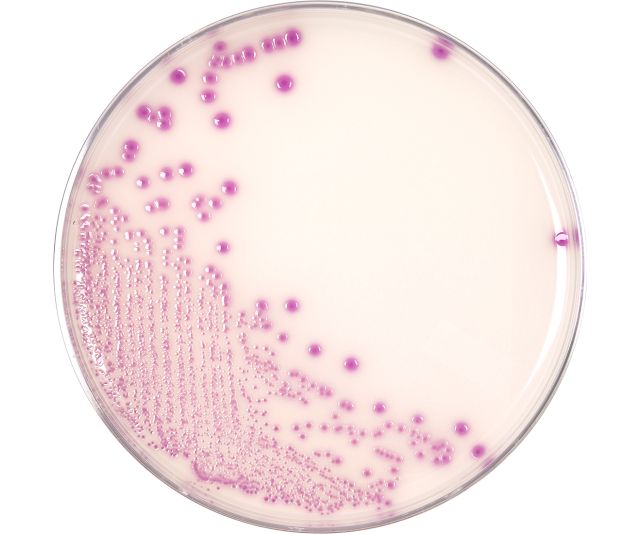

1
/
of
1
Hardy Diagnostics
HardyCHROM O157 (E. coli O157), Chromogenic Medium, 15x100mm Plate, 10 per package
HardyCHROM O157 (E. coli O157), Chromogenic Medium, 15x100mm Plate, 10 per package
Regular price
$63.48 USD
Regular price
Sale price
$63.48 USD
Unit price
/
per
Couldn't load pickup availability
HardyCHROM™ O157 is a selective and differential medium recommended for the isolation of enterohemorrhagic E. coli O157 from food and environmental sources. Chromogenic substances in the media facilitate detection by colony color. Not for human diagnostic use.
Features & Benefits:
- HardyCHROM™ O157 provides an initial screen intended to isolate colonies for further testing.
- Confirm isolated purple-pink colonies with a latex aggulation test, antisera, or other test methods for complete identification.
This media is to be stored and incubated in the dark. If you have a light in your refrigerator or incubator, or you leave the media exposed to light on the bench top, Hardy Diagnostics offers free Blok-Boxes. Blok-Box is a reusable cardboard box that holds one sleeve of ten petri plates.
Share